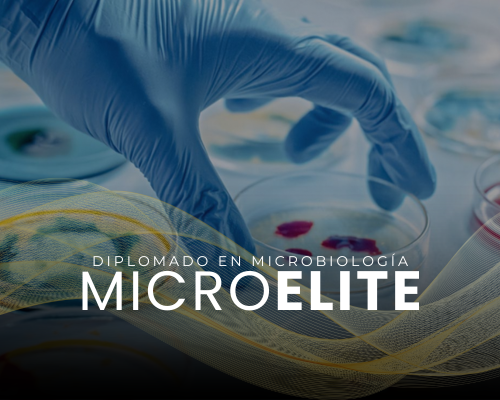
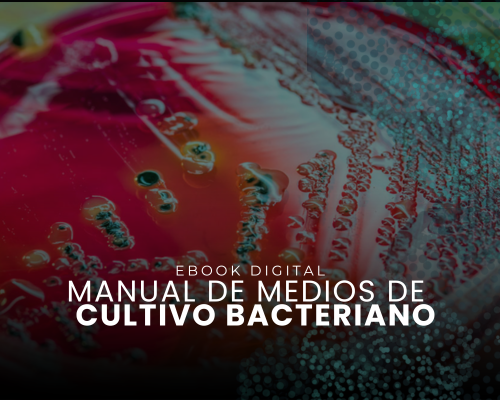

La Formación
Le dimos la vuelta al mundo de la capacitación y formación tradicional en Análisis Clínicos
Enrique Molina, CEO.
Diplomados
La formación estrella de nuestro centro para despertar tu potencial clínico, optimizar tus resultados en el laboratorio y llevar tu carrera al siguiente nivel.
Formaciones para Diplomados
Cursos
Nuestros cursos destacados te brindan la oportunidad de expandir tus capacidades clínicas, perfeccionar tus técnicas de laboratorio y avanzar hacia nuevas metas en tu carrera profesional.
Cursos
Librería Digital
Explora nuestra Librería Digital, un espacio creado para profesionales que buscan seguir aprendiendo. Aquí encontrarás ebooks, atlas y guías especializadas diseñadas para fortalecer tus conocimientos y apoyar tu práctica clínica y de laboratorio.